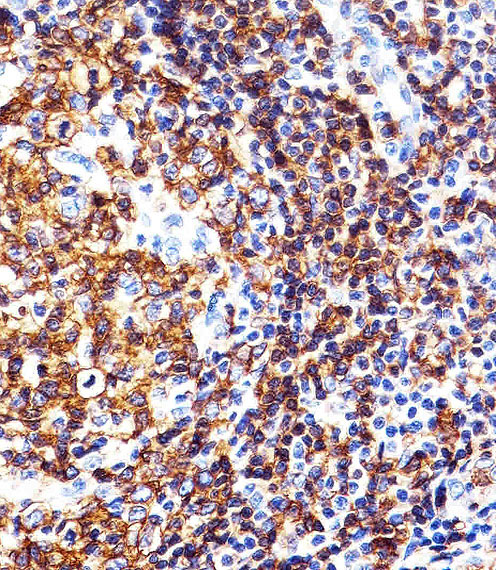

> Antigen, Antibodies, ELISA, Western Blot > Primary Antibody > Polyclonal Antibodies > HLA-DRB1 Antibody (Center)Brand |
Leading Biology | Catalog Number |
APR04623G |
Product Type |
Polyclonal Antibodies | Field of Research |
|
Product Overview |
We constantly strive to ensure we provide our customers with the best antibodies. As a result of this work we offer this antibody in purified format.
We are in the process of updating our datasheets. If you have any questions regarding this update, please feel free to contact our technical support team.
This product is a high quality HLA-DRB1 Antibody (Center).
|
||
Molecular Weight |
29914 Da
|
||
Cellular Localization |
Antigen Cellular Localization:
Cell membrane; Single-pass type I membrane protein Endoplasmic reticulum membrane; Single-pass type I membrane protein Golgi apparatus, trans-Golgi network membrane; Single-pass type I membrane protein. Endosome membrane; Single-pass type I membrane protein. Lysosome membrane; Single-pass type I membrane protein. Late endosome membrane; Single-pass type I membrane protein. Note=The MHC class II complex transits through a number of intracellular compartments in the endocytic pathway until it reaches the cell membrane for antigen presentation
|
||
Host |
Rabbit
|
||
Species Reactivity |
Human
|
||
Target |
This HLA-DRB1 antibody is generated from a rabbit immunized with a KLH conjugated synthetic peptide between 103-137 amino acids from the Central region of human HLA-DRB1.
|
||
Isotype |
Rabbit Ig
|
||
UniProt ID |
|||
Function |
Binds peptides derived from antigens that access the endocytic route of antigen presenting cells (APC) and presents them on the cell surface for recognition by the CD4 T-cells. The peptide binding cleft accommodates peptides of 10-30 residues. The peptides presented by MHC class II molecules are generated mostly by degradation of proteins that access the endocytic route; where they are processed by lysosomal proteases and other hydrolases. Exogenous antigens that have been endocytosed by the APC are thus readily available for presentation via MHC II molecules; and for this reason this antigen presentation pathway is usually referred to as exogenous. As membrane proteins on their way to degradation in lysosomes as part of their normal turn-over are also contained in the endosomal/lysosomal compartments; exogenous antigens must compete with those derived from endogenous components. Autophagy is also a source of endogenous peptides; autophagosomes constitutively fuse with MHC class II loading compartments. In addition to APCs; other cells of the gastrointestinal tract; such as epithelial cells; express MHC class II molecules and CD74 and act as APCs; which is an unusual trait of the GI tract. To produce a MHC class II molecule that presents an antigen; three MHC class II molecules (heterodimers of an alpha and a beta chain) associate with a CD74 trimer in the ER to form a heterononamer. Soon after the entry of this complex into the endosomal/lysosomal system where antigen processing occurs; CD74 undergoes a sequential degradation by various proteases; including CTSS and CTSL; leaving a small fragment termed CLIP (class-II-associated invariant chain peptide). The removal of CLIP is facilitated by HLA-DM via direct binding to the alpha-beta-CLIP complex so that CLIP is released. HLA-DM stabilizes MHC class II molecules until primary high affinity antigenic peptides are bound. The MHC II molecule bound to a peptide is then transported to the cell membrane surface. In B-cells; the interaction between HLA-DM and MHC class II molecules is regulated by HLA-DO. Primary dendritic cells (DCs) also to express HLA-DO. Lysosomal microenvironment has been implicated in the regulation of antigen loading into MHC II molecules; increased acidification produces increased proteolysis and efficient peptide loading.
|
||
Summary |
Binds peptides derived from antigens that access the endocytic route of antigen presenting cells (APC) and presents them on the cell surface for recognition by the CD4 T-cells. The peptide binding cleft accommodates peptides of 10-30 residues. The peptides presented by MHC class II molecules are generated mostly by degradation of proteins that access the endocytic route; where they are processed by lysosomal proteases and other hydrolases. Exogenous antigens that have been endocytosed by the APC are thus readily available for presentation via MHC II molecules; and for this reason this antigen presentation pathway is usually referred to as exogenous. As membrane proteins on their way to degradation in lysosomes as part of their normal turn-over are also contained in the endosomal/lysosomal compartments; exogenous antigens must compete with those derived from endogenous components. Autophagy is also a source of endogenous peptides; autophagosomes constitutively fuse with MHC class II loading compartments. In addition to APCs; other cells of the gastrointestinal tract; such as epithelial cells; express MHC class II molecules and CD74 and act as APCs; which is an unusual trait of the GI tract. To produce a MHC class II molecule that presents an antigen; three MHC class II molecules (heterodimers of an alpha and a beta chain) associate with a CD74 trimer in the ER to form a heterononamer. Soon after the entry of this complex into the endosomal/lysosomal system where antigen processing occurs; CD74 undergoes a sequential degradation by various proteases; including CTSS and CTSL; leaving a small fragment termed CLIP (class-II-associated invariant chain peptide). The removal of CLIP is facilitated by HLA-DM via direct binding to the alpha-beta-CLIP complex so that CLIP is released. HLA-DM stabilizes MHC class II molecules until primary high affinity antigenic peptides are bound. The MHC II molecule bound to a peptide is then transported to the cell membrane surface. In B-cells; the interaction between HLA-DM and MHC class II molecules is regulated by HLA-DO. Primary dendritic cells (DCs) also to express HLA-DO. Lysosomal microenvironment has been implicated in the regulation of antigen loading into MHC II molecules; increased acidification produces increased proteolysis and efficient peptide loading.
|
||
Storage & Stability |
Store at +4°C short term. For long-term storage, aliquot and store at -20°C or below. Stable for 12 months at -20°C. Avoid repeated freeze-thaw cycles.
|
||
Applications |
WB, IHC-P, E
|
||
Dilution |
IHC-P~~1:25
WB~~1:1000
|
||
Images |

Immunohistochemical analysis of paraffin-embedded H. spleen section using HLA-DRB1 Antibody (Center)( APR04623G). APR04623G was diluted at 1:25 dilution. A peroxidase-conjugated goat anti-rabbit IgG at 1:400 dilution was used as the secondary antibody, followed by DAB staining.
Immunohistochemical analysis of paraffin-embedded H. tonsil section using HLA-DRB1 Antibody (Center)( APR04623G). APR04623G was diluted at 1:25 dilution. A peroxidase-conjugated goat anti-rabbit IgG at 1:400 dilution was used as the secondary antibody, followed by DAB staining. 
Western blot analysis of lysates from Daudi, Raji, Ramos cell line and houman spleen tissue lysate (from left to right), using HLA-DRB1 Antibody (Center) (APR04623G). APR04623G was diluted at 1:1000 at each lane. A goat anti-rabbit IgG H&L(HRP) at 1:5000 dilution was used as the secondary antibody. Lysates at 35ug per lane. |
||
Specification |
|||
Quantity |
|
||
| Select | Brand | Catalog No. | Product Name | Pack Size | Type | Field of Research | Specification | Quantity | Price(USD) | |
| 1 | Leading Biology | APR03440G | ITGA11 Antibody (N-term) | 100 μl | Polyclonal Antibodies |
|
$495.00 | Add Ask | ||
| 2 | Leading Biology | APR04537G | CMIP Antibody (C-term) | 100 μl | Polyclonal Antibodies |
|
$495.00 | Add Ask | ||
| 3 | Leading Biology | APR12422G | Human H4 Histamine Receptor (extracellular) Antibody | 50 μl | Polyclonal Antibodies |
|
$695.00 | Add Ask | ||
| 4 | Leading Biology | APR03844G | UBE2W Antibody (C-term) | 100 μl | Polyclonal Antibodies |
|
$495.00 | Add Ask | ||
| 5 | Leading Biology | APR04349G | HECTD2 Antibody (N-term) | 100 μl | Polyclonal Antibodies |
|
$495.00 | Add Ask | ||
| 6 | Leading Biology | APR03502G | IGHG1 Antibody (Center) | 100 μl | Polyclonal Antibodies |
|
$495.00 | Add Ask |
 Leading Biology Inc.
2600 Hilltop DR, Building G, B Suite C138
Richmond, CA, 94806
Tel: 1-661-524(LBI)-0262
Email: info@leadingbiology.com
Leading Biology Inc.
2600 Hilltop DR, Building G, B Suite C138
Richmond, CA, 94806
Tel: 1-661-524(LBI)-0262
Email: info@leadingbiology.com
Complete this form and click send to ask us a question, request a quote or simply say hello.

You have 0 item in your cart

You have 0 item in your inquiry list
